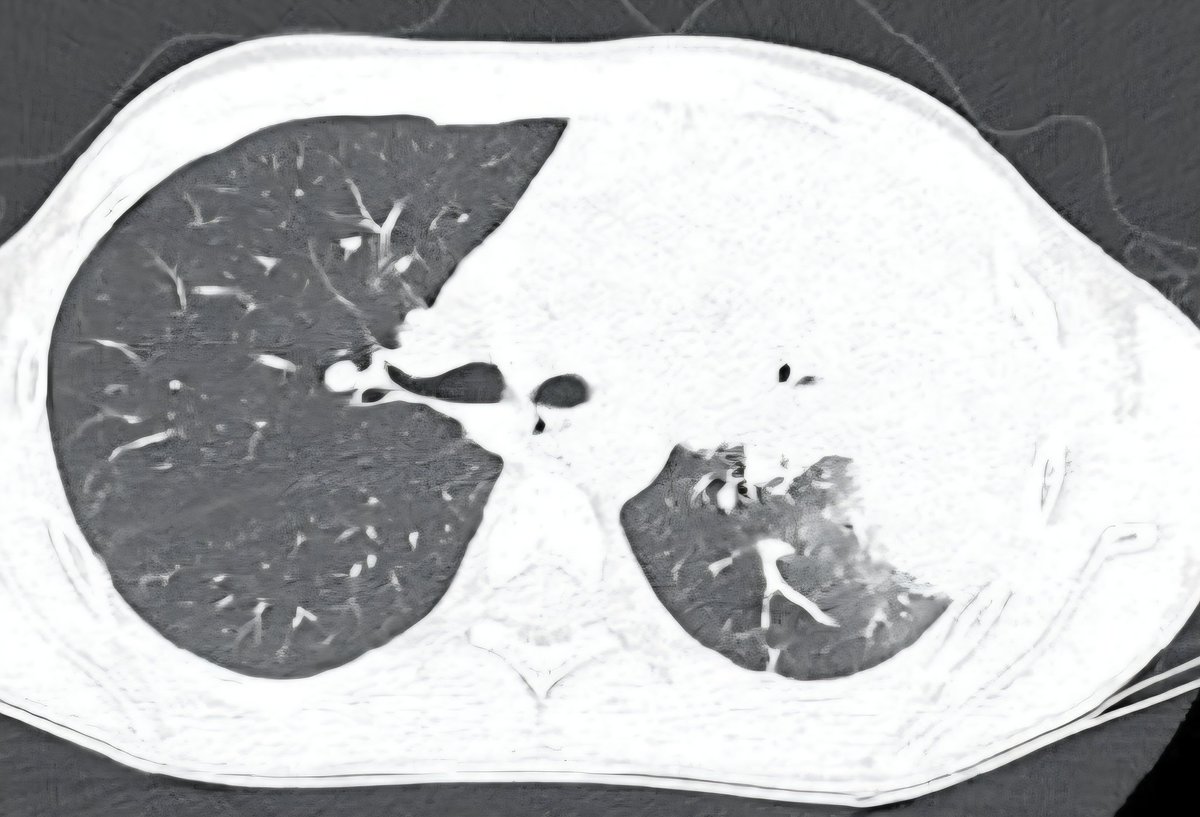
draceciferrario's tweet image. How often have you seen pediatric pneumonias extending to the chest wall? 🤔

#Radiology #PedsRad #CT #MedTwitter

#pedsrad search results
🍽️ Lunch & AI Breakout Session Thank you to our @PhilipsHealth representatives for sponsoring today’s focus on AI in #pedineurorad And to our MD speakers Christopher Filippi (@SickKidsNews), Jeffrey Miller (@PhxChildrens), & Ichiro Ikuta (@MayoRadiologyAZ)! #ASPNR26 #pedsrad




#RadRes, come learn more about the #PedsRad job landscape, @ABR_Radiology pathways for certification & more. 👧🏻 👦🏿 👧🏼 #ACR2024 Happening NOW in Columbia 5 & 7 with Richard Barth, MD, FACR

Dr. Sumit Pruthi from @VUMChealth discusses the importance of nomenclature and clarity in reporting for non-accidental head trauma. #pedineurorad #pedsrad #radres #FOAMrad




Dr Rebekah Clarke from UT Southwestern heats it the rapid fire section with compelling cases of abusive head trauma 🔥#pedineurorad #ASPNR26 #pedsrad #radres #MedEd




Don’t sit down quite yet after that standing ovation! Give another big round of applause for our new fellows of the @The_ASPNR! 👏🏽 Congratulations to the class of ‘26! 🍾🎉🎊 #ASPNR26 #pedineurorad #pedsrad


Looking for standardized report templates for #neuro and #PedsRad #IRad procedures? The new version 3.1 standardized reports has just launched, and information can be found on our webpage: sirweb.org/practice-resou…
How often have you seen pediatric pneumonias extending to the chest wall? 🤔 #Radiology #PedsRad #CT #MedTwitter

🎉Congratulations to all of the brilliant doctors that matched in #Radiology @EmoryMedicine! 👏 We look forward sharing the most interesting & rewarding subspecialties with you- #PedsRad, #PediNeuroRad & #PedsIR! Welcome to @ChildrensATL! #Match2026 @SocPedRad @The_ASPNR




#SPR25 Join us for interactive unknown case session DUNES (too much of something) to DESOLATION (too little of something) @ 4pm Coral 4 w/Drs Leann Linam, Alex El-Ali, Govind Chavhan, Lindsay Griffin, Madhavi Jayachandra, Sam Gerrie, Stacey Elangovan, Michael Acord & me #pedsrad

Thats @pseudo0220 of @CincyKidsRad head of our #nucmed section and expert in all things #pediatric nucmed but especially MIBG #pedsrad
Susan Sharp, MD talks about the potential of I-131-MIBG therapy for neuroblastoma:
A big congrats to your father @towbinaj, well-deserved!! We are so grateful to you and your father for all of your help and contributions to our #PedsRad community! #medicalstudent #futureradres #radres #meded

Congratulations to Dr. Chris Anton for winning the Outstanding Educator Award!

#PittPedsRad would like to welcome new #PedsRad-in-Chief @RadRupa who joins us from @IURadiology where she was Section Chief of #NeuroRadiology. Special thanks Dr. Sheila Moore for serving as Interim Chief during the Chief search! #Radleaders #PediNeuroRad @PittRadiology

Congratulations to Dr. Shailee Lala, @NYUImaging Pediatric Imaging Section Chief, on her new role as an Assistant Editor of Pediatric Radiology! #radiology #pedsrad
@SocPedRad joins the Editors (The Americas) of @PedRadJournal in congratulating Dr. Shailee Lala, who joins the team as an Assistant Editor for the Americas. The SPR also wishes to thank Dr. Sjirk Westra for his service as Assistant Editor. #imagingourfuture

Exciting news from @ABR_Radiology for all #futureradres! 👏 to @SocPedRad for helping make this happen. @ACRRFS @futureradres #pedsrad #pedrad #Medstudent #ImagingOurFuture
Big news for radiology residents: ABR approves 15 month pathway for pediatric radiology. Get board certified for pedi while doing your residency a la nucs! theabr.org/diagnostic-rad…
Four generations of CHOA peds rad fellows all in one reading room today 🥰 #PedsRad #Radiologists #WomenInMedicine @childrensatl @EmoryMedicine @RadiologyChicks @SocPedRad

A great leader is a good listener! Thanks Donna Hyland CEO @childrensatl for a fun & productive evening! #pediatrics #radiology #pedsrad #pedineurorad

Something went wrong.
Something went wrong.
United States Trends
- 1. Good Saturday N/A
- 2. #Caturday N/A
- 3. #LoveYouTeacherSeriesEP7 N/A
- 4. Woodman N/A
- 5. Falklands N/A
- 6. #BrokenOfLoveEP5 N/A
- 7. Mali N/A
- 8. #LIVCRY N/A
- 9. Robbo N/A
- 10. Ann Li N/A
- 11. LOVE OUT OF CONTROL N/A
- 12. #ERBday2026 N/A
- 13. Senior Day N/A
- 14. THE WATER TRUTH REVEALED N/A
- 15. Argentina N/A
- 16. Kolo Muani N/A
- 17. Exercise N/A
- 18. Allar N/A
- 19. LINGORM X NOOM KANCHAI N/A
- 20. Kyle Louis N/A



















